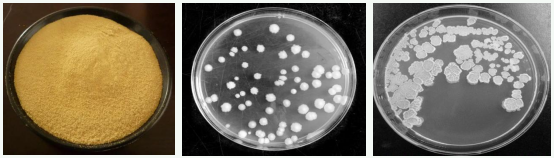

Introductions:
Bacillus amyloliquefaciens is a genus of Bacillus that is highly related to Bacillus subtilis.It is easy to reproduce, has strong adaptability to the environment, and can produce a series of metabolites that can inhibit fungal and bacterial activity during the growth process.
Product Features

Scope of Application


Ms Wendy Lee
Mobile&Wechat&Whatsapp : 0086 13562692198
Email :yuedongbiotech@aliyun.com
Ms Jeff Wang
Mobile&Wechat&Whatsapp : 0086 13563622867
Email :wfyuedong@aliyun.com
Ms Sundy Lee
Mobile&Wechat&Whatsapp : 0086 15965090376
Email :yuedongsundy@aliyun.com


